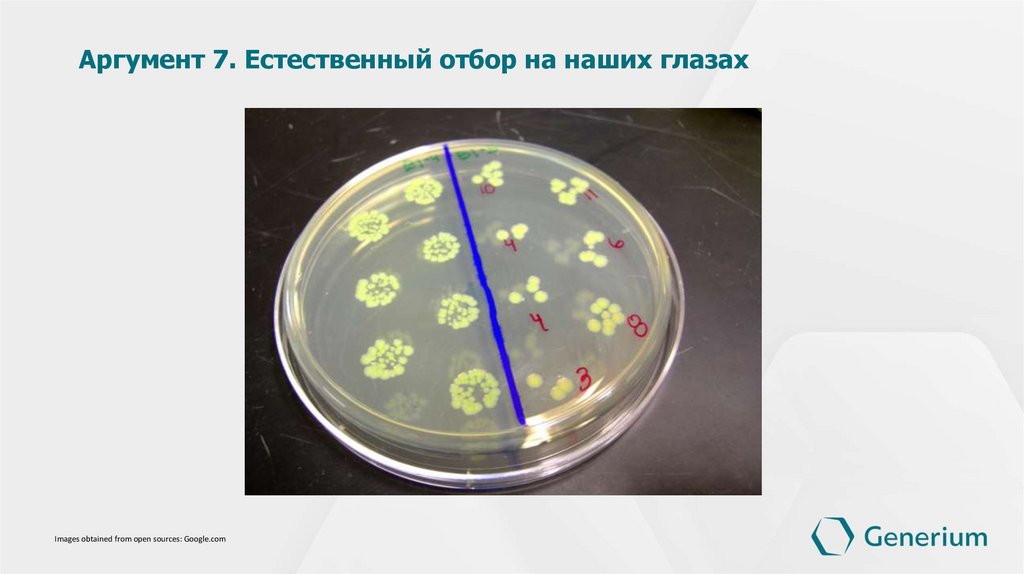

Похожие презентации:
Эволюция
1.
Why Evolution is TruePh.D., researcher, Funtikov A.A.
2.
Аргумент 1. Палеонтологическая летописьImages obtained from open sources: Google.com
3.
Аргумент 2. Древовидная иерархия видовImages obtained from open sources: Google.com
4.
Аргумент 3. Несовершенство жизненных формImages obtained from open sources: Google.com
5.
Аргумент 4. Рудименты и атавизмыImages obtained from open sources: Google.com
6.
Аргумент 5. Связь биологии с географиейImages obtained from open sources: Google.com
7.
Аргумент 6. Конвергентная эволюцияImages obtained from open sources: Google.com
8.
Аргумент 7. Естественный отбор на наших глазахImages obtained from open sources: Google.com
9.
Аргумент 8. Средства привлечения партнёраImages obtained from open sources: Google.com
10.
Аргумент 9. Отсутствие убедительных альтернативных теорийImages obtained from open sources: Google.com
11.
Аргумент 10. Научный статус теорииImages obtained from open sources: Google.com
12.
Спасибо завнимание
www.generium.ru

Биология
Биология История
История








